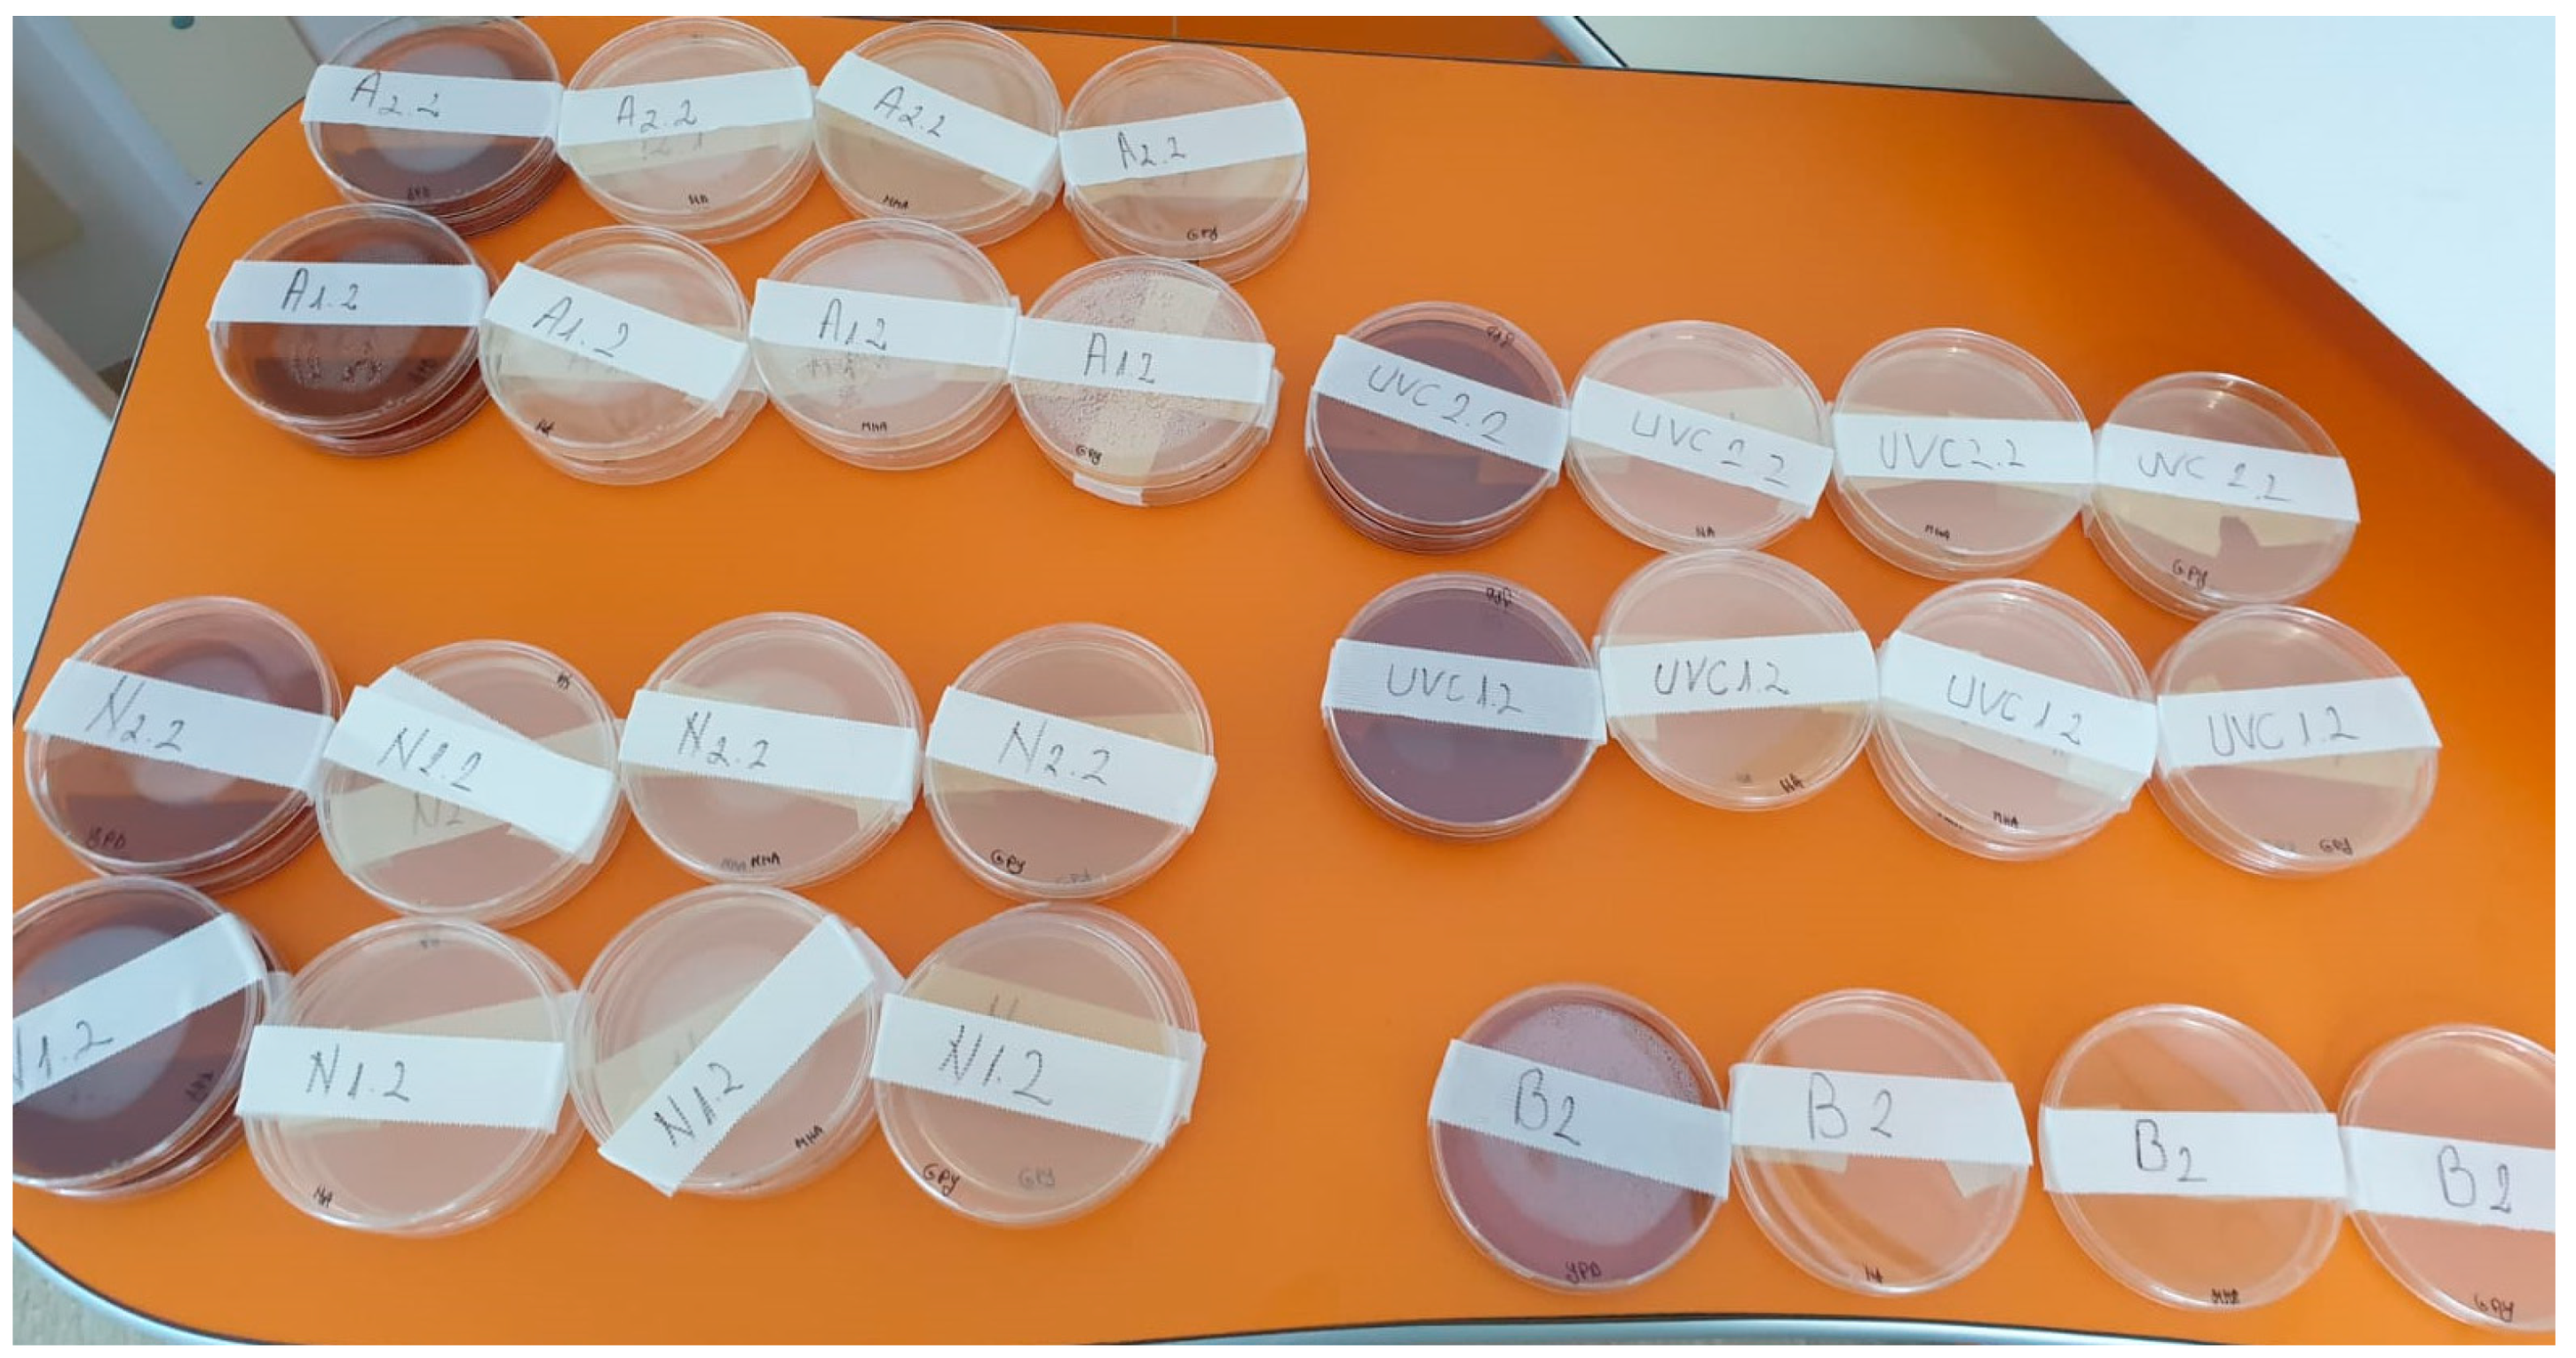

The Importance of Atmospheric Microbial Contamination Control in Dental Offices: Raised Awareness Caused by the SARS-CoV-2 Pandemic
Abstract
Featured Application
Abstract
1. Introduction
2. Materials and Methods
3. Results
4. Discussion
5. Conclusions
Author Contributions
Funding
Institutional Review Board Statement
Informed Consent Statement
Acknowledgments
Conflicts of Interest
References
- Valencia, D.N. Brief Review on COVID-19: The 2020 Pandemic Caused by SARS-CoV-2. Cureus 2020, 12, e7386. [Google Scholar] [CrossRef]
- Cervino, G.; Fiorillo, L.; Surace, G.; Paduano, V.; Fiorillo, M.T.; De Stefano, R.; Laudicella, R.; Baldari, S.; Gaeta, M.; Cicciù, M. SARS-CoV-2 Persistence: Data Summary up to Q2 2020. Data 2020, 5, 81. [Google Scholar] [CrossRef]
- D’Errico, S.; Zanon, M.; Montanaro, M.; Radaelli, D.; Sessa, F.; Di Mizio, G.; Montana, A.; Corrao, S.; Salerno, M.; Pomara, C. More than Pneumonia: Distinctive Features of SARS-Cov-2 Infection. From Autopsy Findings to Clinical Implications: A Systematic Review. Microorganisms 2020, 8, 1642. [Google Scholar] [CrossRef] [PubMed]
- Contini, C.; Caselli, E.; Martini, F.; Maritati, M.; Torreggiani, E.; Seraceni, S.; Vesce, F.; Perri, P.; Rizzo, L.; Tognon, M. COVID-19 Is a Multifaceted Challenging Pandemic Which Needs Urgent Public Health Interventions. Microorganisms 2020, 8, 1228. [Google Scholar] [CrossRef]
- Cervino, G.; Oteri, G. COVID-19 Pandemic and Telephone Triage before Attending Medical Office: Problem or Opportunity? Medicina 2020, 56, 250. [Google Scholar] [CrossRef] [PubMed]
- Day, C.J.; Sandy, J.R.; Ireland, A.J. Aerosols and splatter in dentistry–A neglected menace? Dent. Update 2006, 33, 601–606. [Google Scholar] [CrossRef]
- Fini, M.B. What dentists need to know about COVID-19. Oral Oncol. 2020, 105, 104741. [Google Scholar] [CrossRef] [PubMed]
- Bordea, I.R.; Xhajanka, E.; Candrea, S.; Bran, S.; Onișor, F.; Inchingolo, A.D.; Malcangi, G.; Pham, V.H.; Inchingolo, A.M.; Scarano, A.; et al. Coronavirus (SARS-CoV-2) Pandemic: Future Challenges for Dental Practitioners. Microorganisms 2020, 8, 1704. [Google Scholar] [CrossRef] [PubMed]
- Balakrishnan, K.; Schechtman, S.; Hogikyan, N.D.; Teoh, A.Y.B.; McGrath, B.; Brenner, M.J. COVID-19 Pandemic: What Every Otolaryngologist–Head and Neck Surgeon Needs to Know for Safe Airway Management. Otolaryngol. Head Neck Surg. 2020, 162, 804–808. [Google Scholar] [CrossRef]
- Dimitriu, M.C.T.; Pantea-Stoian, A.; Smaranda, A.C.; Nica, A.A.; Carap, A.C.; Constantin, V.D.; Davitoiu, A.M.; Cirstoveanu, C.; Bacalbasa, N.; Bratu, O.G.; et al. Burnout syndrome in Romanian medical residents in time of the COVID-19 pandemic. Med. Hypotheses 2020, 144, 109972. [Google Scholar] [CrossRef]
- Szymańska, J. Endotoxin level as a potential marker of concentration of Gram-negative bacteria in water effluent from dental units and in dental aerosols. Ann. Agric. Environ. Med. 2005, 12, 229–232. [Google Scholar]
- Fine, D.H.; Furgang, D.; Korik, I.; Olshan, A.; Barnett, M.L.; Vincent, J.W. Reduction of viable bacteria in dental aerosols by preprocedural rinsing with an antiseptic mouthrinse. Am. J. Dent. 1993, 6, 219–221. [Google Scholar] [PubMed]
- Al Maghlouth, A.; Al Yousef, Y.; Al Bagieh, N. Qualitative and quantitative analysis of bacterial aerosols. J. Contemp. Dent. Pract. 2004, 5, 91–100. [Google Scholar] [CrossRef]
- Huntley, D.E.; Campbell, J. Bacterial contamination of scrub jackets during dental hygiene procedures. J. Dent. Hyg. JDH 1998, 72, 19–23. [Google Scholar]
- Miller, R.L.; Micik, R.E. Air pollution and its control in the dental office. Dent. Clin. North Am. 1978, 22, 453–476. [Google Scholar]
- Tudose, P.; Wittemberg, T.; Gavrişiu, F.; Luştrea, V. Some imperfections in dental practice. Stomatologia 1972, 19, 109–116. [Google Scholar] [PubMed]
- Iversen, D.B.; Tolo, K. Electrostatic air filters for dental practice. Nor Tann. Tid. 1975, 85, 446–448. [Google Scholar]
- Shreve, W.B.; Wachtel, L.W.; Pelleu, G.B., Jr. Air cleaning devices for reduction in number of airborne bacteria. J. Dent. Res. 1970, 49, 1078–1082. [Google Scholar] [CrossRef]
- Luksamijarulkul, P.; Panya, N.; Sujirarat, D.; Thaweboon, S. Microbial air quality and standard precaution practice in a hos-pital dental clinic. J. Med. Assoc. Thai. 2009, 92 (Suppl. S7), S148–S155. [Google Scholar] [PubMed]
- Dagher, J.; Sfeir, C.; Abdallah, A.; Majzoub, Z. Sterilization and Biologic Monitoring in Private Dental Clinics in Lebanon. J. Contemp. Dent. Pract. 2018, 19, 853–861. [Google Scholar]
- Harrel, S.K.; Molinari, J. Aerosols and splatter in dentistry: A brief review of the literature and infection control implications. J. Am. Dent. Assoc. 2004, 135, 429–437. [Google Scholar] [CrossRef]
- Yamada, H.; Ishihama, K.; Yasuda, K.; Hasumi-Nakayama, Y.; Shimoji, S.; Furusawa, K. Aerial dispersal of blood-contaminated aerosols during dental procedures. Quintessence Int. 2011, 42, 399–405. [Google Scholar] [PubMed]
- Monarca, S.; Grottolo, M.; Feretti, D.; Gigola, P.; Zerbini, I.; Alberti, A.; Zani, C.; Sapelli, P.L. Environmental monitoring of infective risks in Italian dental offices. Minerva Stomatol. 2002, 51, 319–326. [Google Scholar] [PubMed]
- Piazza, M.; Borgia, G.; Picciotto, L.; Nappa, S.; Cicciarello, S.; Orlando, R. Detection of hepatitis C virus-RNA by polymerase chain reaction in dental surgeries. J. Med. Virol. 1995, 45, 40–42. [Google Scholar] [CrossRef] [PubMed]
- Zhou, S.S.; Lukula, S.; Chiossone, C.; Nims, R.W.; Suchmann, D.B.; Ijaz, M.K. Assessment of a respiratory face mask for capturing air pollutants and pathogens including human influenza and rhinoviruses. J. Thorac. Dis. 2018, 10, 2059–2069. [Google Scholar] [CrossRef] [PubMed]
- Signoretto, C.; Canepari, P.; Urbani, G. Microbiological contamination in the dental office and its possible decrease. Minerva Stomatol. 1994, 43, 263–272. [Google Scholar]
- Shivakumar, K.M.; Prashant, G.M.; Madhu Shankari, G.S.; Subba Reddy, V.V.; Chandu, G.N. Assessment of atmospheric microbial contamination in a mobile dental unit. Indian J. Dent. Res. 2007, 18, 177–180. [Google Scholar] [CrossRef]
- Eisenlöffel, L.; Reutter, T.; Horn, M.; Schlegel, S.; Truyen, U.; Speck, S. Impact of UVC-sustained recirculating air filtration on airborne bacteria and dust in a pig facility. PLoS ONE 2019, 14, e0225047. [Google Scholar] [CrossRef]
- Curtis, G.L.; Faour, M.; Jawad, M.; Klika, A.K.; Barsoum, W.K.; Higuera, C.A. Reduction of Particles in the Operating Room Using Ultraviolet Air Disinfection and Recirculation Units. J. Arthroplast. 2018, 33, S196–S200. [Google Scholar] [CrossRef]
- Kim, D.-K.; Kang, D.-H. UVC LED Irradiation Effectively Inactivates Aerosolized Viruses, Bacteria, and Fungi in a Chamber-Type Air Disinfection System. Appl. Environ. Microbiol. 2018, 84, e00944–18. [Google Scholar] [CrossRef]
- Szymańska, J. Exposure to airborne fungi during conservative dental treatment. Ann. Agric. Environ. Med. 2006, 13, 177–179. [Google Scholar]
- Te Velthuis, A.J.W.; van den Worm, S.H.E.; Sims, A.C.; Baric, R.S.; Snijder, E.J.; Van Hemert, M.J. Zn(2+) inhibits coronavirus and arterivirus RNA polymerase activity in vitro and zinc ionophores block the replication of these viruses in cell culture. PLoS Pathog. 2010, 6, e1001176. [Google Scholar] [CrossRef]
- Schwartz, J.R. Zinc Pyrithione: A Topical Antimicrobial With Complex Pharmaceutics. J. Drugs Dermatol. JDD 2016, 15, 140–144. [Google Scholar]
- Tang, S.; Mao, Y.; Jones, R.M.; Tan, Q.; Ji, J.S.; Li, N.; Shen, J.; Lv, Y.; Pan, L.; Ding, P.; et al. Aerosol transmission of SARS-CoV-2? Evidence, prevention and control. Environ. Int. 2020, 144, 106039. [Google Scholar] [CrossRef]
- Correa-Martínez, C.L.; Schwierzeck, V.; Mellmann, A.; Hennies, M.; Kampmeier, S. Healthcare-Associated SARS-CoV-2 Transmission—Experiences from a German University Hospital. Microorganisms 2020, 8, 1378. [Google Scholar] [CrossRef] [PubMed]
- Dar Odeh, N.; Babkair, H.; Abu-Hammad, S.; Borzangy, S.; Abu-Hammad, A.; Abu-Hammad, O. COVID-19: Present and Future Challenges for Dental Practice. Int. J. Environ. Res. Public Health 2020, 17, 3151. [Google Scholar] [CrossRef] [PubMed]
- Mick, P.; Murphy, R. Aerosol-generating otolaryngology procedures and the need for enhanced PPE during the COVID-19 pandemic: A literature review. J. Otolaryngol. Head Neck Surg. 2020, 49, 1–10. [Google Scholar] [CrossRef]
- Ali, S.; Farooq, I.; Abdelsalam, M.; AlHumaid, J. Current Clinical Dental Practice Guidelines and the Financial Impact of COVID-19 on Dental Care Providers. Eur. J. Dent. 2020, 14, S140–S145. [Google Scholar] [CrossRef]
- Schwendicke, F.; Krois, J.; Gomez, J. Impact of SARS-CoV2 (Covid-19) on dental practices: Economic analysis. J. Dent. 2020, 99, 103387. [Google Scholar] [CrossRef] [PubMed]
- Bounoure, F.; Fiquet, H.; Arnaud, P. Comparison of hydrogen peroxide and peracetic acid as isolator sterilization agents in a hospital pharmacy. Am. J. Health Syst. Pharm. 2006, 63, 451–455. [Google Scholar] [CrossRef] [PubMed]
- Cutts, T.; Kasloff, S.; Safronetz, D.; Krishnan, J. Decontamination of common healthcare facility surfaces contaminated with SARS-CoV-2 using peracetic acid dry fogging. J. Hosp. Infect. 2021, 109, 82–87. [Google Scholar] [CrossRef]
- Schinköthe, J.; Scheinemann, H.A.; Diederich, S.; Freese, H.; Eschbaumer, M.; Teifke, J.P.; Reiche, S. Airborne Disinfection by Dry Fogging Efficiently Inactivates Severe Acute Respiratory Syndrome Coronavirus 2 (SARS-CoV-2), Mycobacteria, and Bacterial Spores and Shows Limitations of Commercial Spore Carriers. Appl. Environ. Microbiol. 2021, 87, e02019-20. [Google Scholar] [CrossRef] [PubMed]
- Yousefshahi, F.; Khajavi, M.R.; Anbarafshan, M.; Khashayar, P.; Najafi, A. Sanosil, a more effective agent for preventing the hospital-acquired ventilator associated pneumonia. Int. J. Health Care Qual. Assur. 2010, 23, 583–590. [Google Scholar] [CrossRef]
- Heilingloh, C.S.; Aufderhorst, U.W.; Schipper, L.; Dittmer, U.; Witzke, O.; Yang, D.; Zheng, X.; Sutter, K.; Trilling, M.; Alt, M.; et al. Susceptibility of SARS-CoV-2 to UV irradiation. Am. J. Infect. Control 2020, 48, 1273–1275. [Google Scholar] [CrossRef] [PubMed]
- Kitagawa, H.; Nomura, T.; Nazmul, T.; Omori, K.; Shigemoto, N.; Sakaguchi, T.; Ohge, H. Effectiveness of 222-nm ultraviolet light on disinfecting SARS-CoV-2 surface contamination. Am. J. Infect. Control 2021, 49, 299–301. [Google Scholar] [CrossRef] [PubMed]

| MHA | Non-selective matching for Haemophilus spp., Enterococcus spp., Escherichia coli, Pseudomonas spp., Staphylococcus spp. and Streptococcus spp. for bacteria (General Media) and for coliforms. |
| NA | Non-selective matching for Enterococcus spp., Escherichia coli, Salmonella spp., Shigella spp. and Staphylococcus spp. for bacteria (General Media) and for coliforms. |
| GPY | Recommended for yeast isolation. |
| YPD | Media for yeast development. Non-selective matching for Candida spp., Pichia spp., Saccharomyces spp. and Zygosaccharomyces spp. |
| Ventilation | Fogging | UVC | UVC Box | |||||
|---|---|---|---|---|---|---|---|---|
| P1 | P2 | P1 | P2 | P1 | P2 | P2 | ||
| During treatment | MHA | + | + | + | + | + | + | + |
| NA | + | + | + | + | + | + | ||
| GPY | + | + | + | |||||
| YPD | + | + | ||||||
| After air decontamination | MHA | + | + | |||||
| NA | ||||||||
| GPY | ||||||||
| YPD | ||||||||
| MHA | NA | GPY | YPD | |
|---|---|---|---|---|
| UVC 1.1 | 1 | 1 | - | - |
| UVC 1.2 | 1 | - | - | - |
| UVC 2.1 | 2 | 1 | - | - |
| A 1.1 | 1 | 3 | - | - |
| A 2.1 | 2 | 1 | 3 | - |
| A 2.2 | 1 | - | - | - |
| B2 | 2 | - | - | - |
| N 1.1 | 14 | 13 | 3 | 1 |
| N 2.1 | 3 | 8 | 2 | 1 |
Publisher’s Note: MDPI stays neutral with regard to jurisdictional claims in published maps and institutional affiliations. |
© 2021 by the authors. Licensee MDPI, Basel, Switzerland. This article is an open access article distributed under the terms and conditions of the Creative Commons Attribution (CC BY) license (http://creativecommons.org/licenses/by/4.0/).
Share and Cite
Manea, A.; Crisan, D.; Baciut, G.; Baciut, M.; Bran, S.; Armencea, G.; Crisan, M.; Colosi, H.; Colosi, I.; Vodnar, D.; et al. The Importance of Atmospheric Microbial Contamination Control in Dental Offices: Raised Awareness Caused by the SARS-CoV-2 Pandemic. Appl. Sci. 2021, 11, 2359. https://doi.org/10.3390/app11052359
Manea A, Crisan D, Baciut G, Baciut M, Bran S, Armencea G, Crisan M, Colosi H, Colosi I, Vodnar D, et al. The Importance of Atmospheric Microbial Contamination Control in Dental Offices: Raised Awareness Caused by the SARS-CoV-2 Pandemic. Applied Sciences. 2021; 11(5):2359. https://doi.org/10.3390/app11052359
Chicago/Turabian StyleManea, Avram, Diana Crisan, Grigore Baciut, Mihaela Baciut, Simion Bran, Gabriel Armencea, Maria Crisan, Horatiu Colosi, Ioana Colosi, Dan Vodnar, and et al. 2021. "The Importance of Atmospheric Microbial Contamination Control in Dental Offices: Raised Awareness Caused by the SARS-CoV-2 Pandemic" Applied Sciences 11, no. 5: 2359. https://doi.org/10.3390/app11052359
APA StyleManea, A., Crisan, D., Baciut, G., Baciut, M., Bran, S., Armencea, G., Crisan, M., Colosi, H., Colosi, I., Vodnar, D., Aghiorghiesei, A., Aghiorghiesei, O., Onisor, F., & Dinu, C. (2021). The Importance of Atmospheric Microbial Contamination Control in Dental Offices: Raised Awareness Caused by the SARS-CoV-2 Pandemic. Applied Sciences, 11(5), 2359. https://doi.org/10.3390/app11052359

